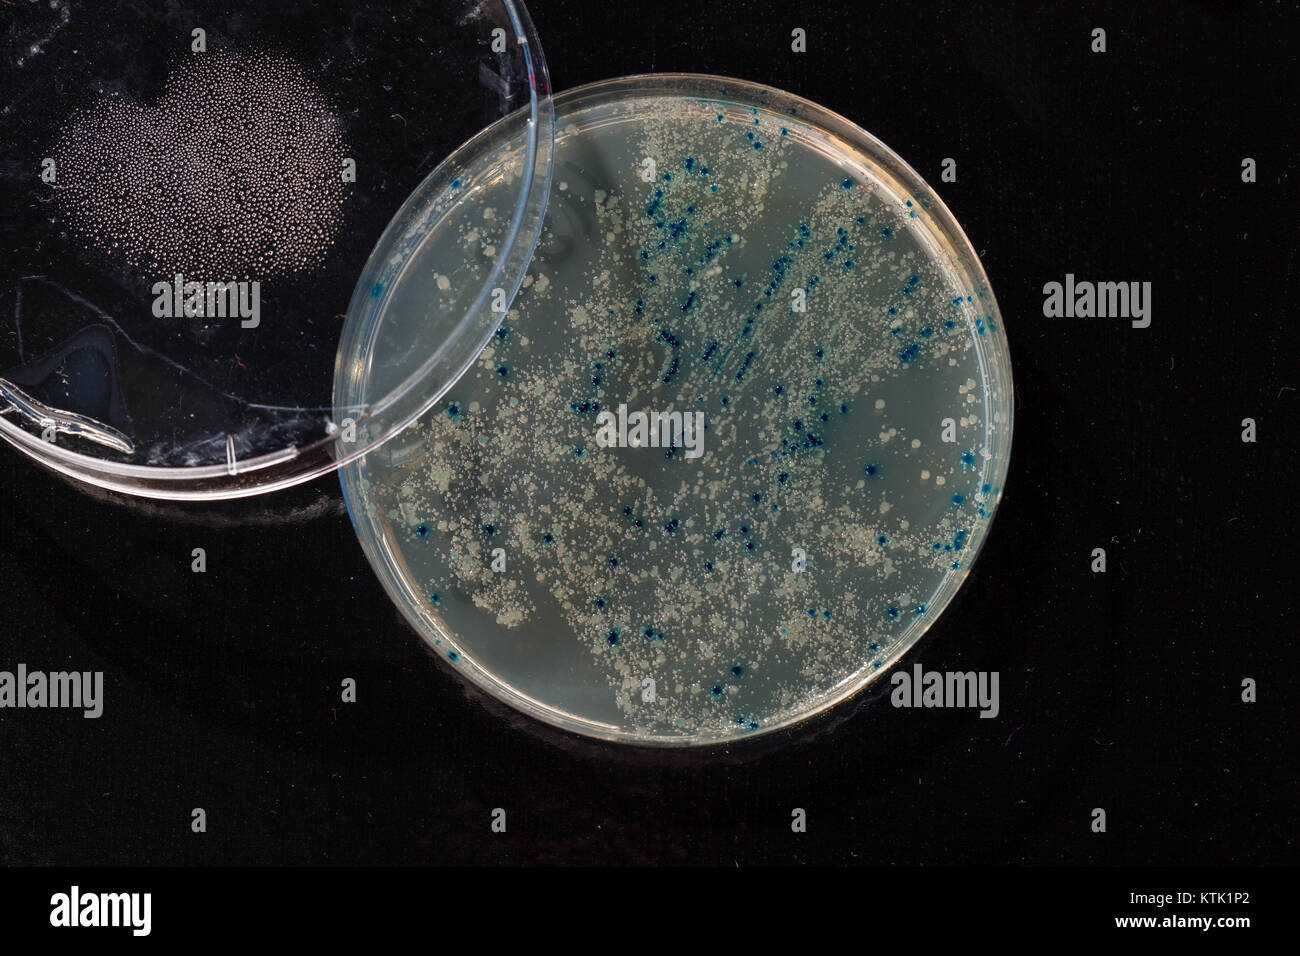
Kolonien in Petrischale Klonen von transgenen Vektor in die Plasmid-DNA Stockfoto
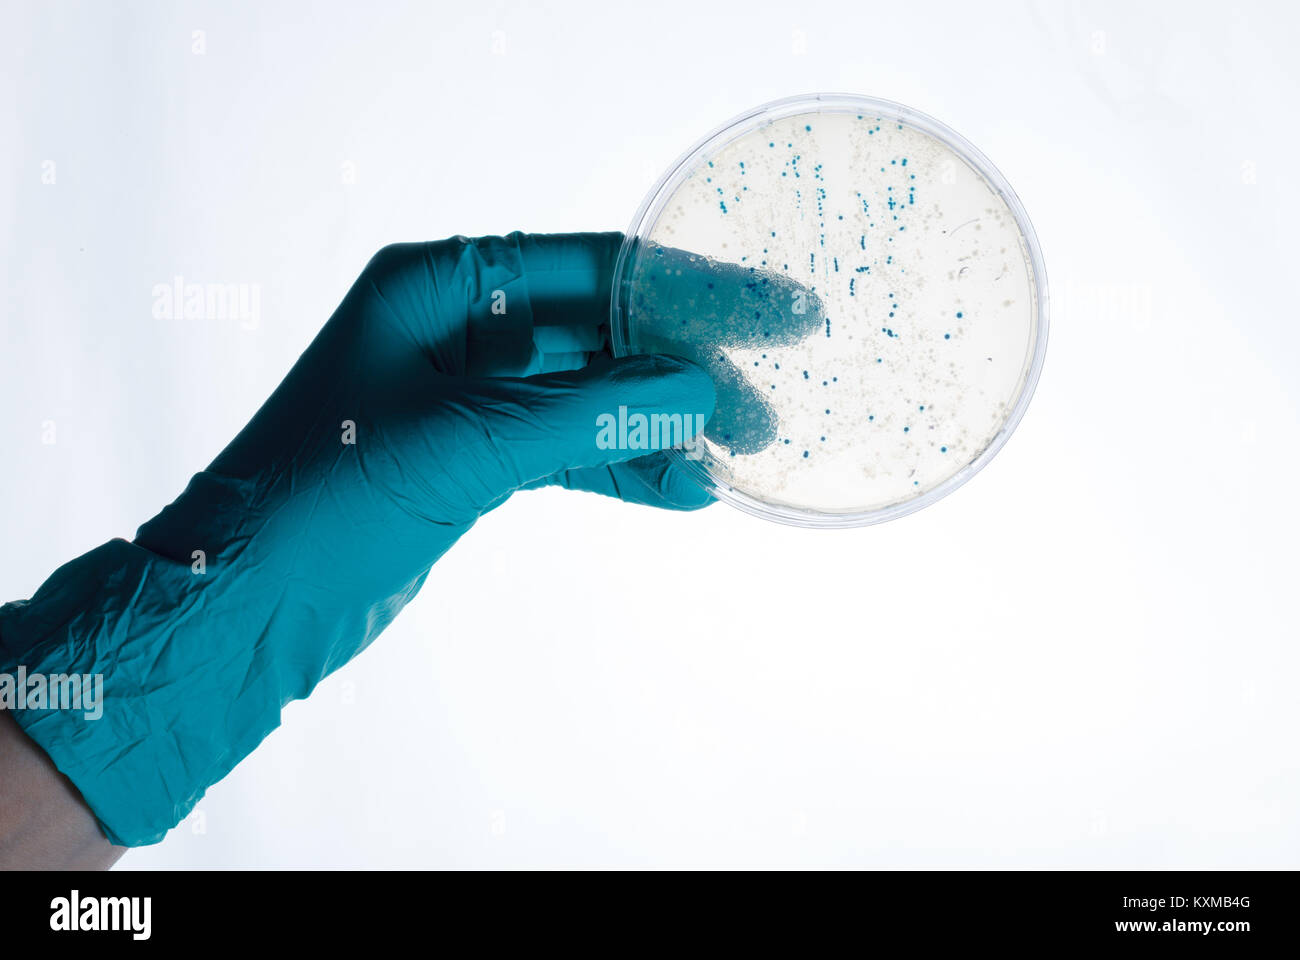
Kolonien in Petrischale Klonen von transgenen Vektor in die Plasmid-DNA Stockfoto

Dna probe Stockfotos & Bilder

RF2BN7GKD–Laden von Samples und läuft einem Agarosegel für Elektrophorese Gelelektrophorese ist der Standard lab Verfahren zur Trennung von DNA

RFKE6ATC–Zentrifuge Reagenzgläser für genetische Identifikation von Eltern, DNA-basierte Identifikation von Menschen QR-Code

RFKETPR4–Zentrifuge Reagenzgläser für genetische Identifikation von Eltern, DNA-basierte Identifikation von Menschen QR-Code

RFKE6ATD–Zentrifuge Reagenzgläser für genetische Identifikation von Eltern, DNA-basierte Identifikation von Menschen QR-Code

RFM1F92H–Wissenschaftler Hand greift Bakterienkolonien für das Klonen von transgenen Vektor in die Plasmid-DNA

RF2FMX5MN–Blutprobenschlauch enthält Stammzellen für Zelltherapieblut Probe im Reagenzglas in ärztlicher Hand im medizinischen Labor

RF2FMX5FX–NIPT- oder nichtinvasive Pränataltests, Diagnose des Testergebnisses für das fetale Down-Syndrom mit Blutprobe im Reagenzglas bei ärztlicher Hand im medizinischen Labor

RFM1GGYW–Wissenschaftler Hand greift Bakterienkolonien für das Klonen von transgenen Vektor in die Plasmid-DNA

RFKXWD8R–Wissenschaftler Hand greift Bakterienkolonien für das Klonen von transgenen Vektor in die Plasmid-DNA

RFPKYNCK–Ein Wissenschaftler in einem medizinischen Labor mit einem Dispenser in seinen Händen ist eine genetische Analyse Proben

RFKETPA3–Mikroskop Thema Tabelle und biologische Proben. Mikroskop ist das wichtigste Instrument in vielen wissenschaftlichen mikrobiologischen Labors